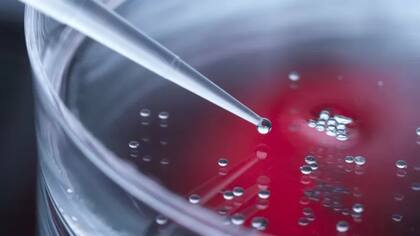

El objetivo final es desarrollar tratamientos para enfermedades relacionadas con la edad, como la diabetes, patologías cardíacas y trastornos neurológicos
6 minutos de lectura'

Investigadores han logrado rejuvenecer las células de la piel de una mujer de 53 años para que sean equivalentes a las de una mujer de 23 años.
Los científicos, de la Universidad de Cambridge, en Reino Unido, creen que pueden hacer lo mismo con otros tejidos del cuerpo.
El objetivo final es desarrollar tratamientos para enfermedades relacionadas con la edad, como la diabetes, patologías cardíacas y trastornos neurológicos.
La tecnología se basa en las técnicas utilizadas para crear a Dolly, la oveja clonada hace más de 25 años.

El jefe del equipo, el profesor Wolf Reik, del Instituto Babraham en Cambridge, le dijo a la BBC que esperaba que la técnica pudiera usarse para mantener a las personas más saludables por más tiempo a medida que envejecen.
“Hemos estado soñando con este tipo de cosas. Muchas enfermedades comunes empeoran con la edad y pensar en ayudar a las personas de esta manera es súper emocionante”, dijo.
Sin embargo, el profesor Reich enfatizó que el trabajo, que se publicó en la revista eLife, se encontraba en una etapa muy temprana.
Dijo que había varios problemas científicos que superar antes de que pudiera salir de su laboratorio y entrar en la clínica. Pero aseguró que demostrar por primera vez que el rejuvenecimiento celular es posible es un paso fundamental.
Siguiendo los pasos de “Dolly”

Los orígenes de la técnica se remontan a la década de 1990, cuando los investigadores del Instituto Roslin, en las afueras de Edimburgo, desarrollaron un método para convertir una célula adulta de la glándula mamaria extraída de una oveja en un embrión.
Condujo a la creación de Dolly, la oveja clonada.
El objetivo del equipo de Roslin no era crear clones de ovejas ni de humanos, sino utilizar la técnica para crear las llamadas células madre embrionarias humanas.
Estas, esperaban, podrían convertirse en tejidos específicos, como músculos, cartílagos y células nerviosas para reemplazar partes del cuerpo desgastadas.
La técnica Dolly fue simplificada en 2006 por el profesor Shinya Yamanaka, entonces en la Universidad de Kyoto.
El nuevo método, llamado IPS, consistía en añadir productos químicos a las células adultas durante unos 50 días.
Esto resultó en cambios genéticos que convirtieron las células adultas en células madre.
Tanto en la técnica de Dolly como en la IPS, las células madre creadas deben volver a crecer en las células y tejidos que el paciente requiera.
Esto ha resultado difícil y, a pesar de décadas de esfuerzos, el uso de células madre para tratar enfermedades actualmente es extremadamente limitado.
Un nuevo método

El equipo del profesor Reik utilizó la técnica IPS en células de piel de 53 años. Pero acortaron el baño químico de 50 días a alrededor de 12.
El doctor Dilgeet Gill se sorprendió al descubrir que las células no se habían convertido en células madre embrionarias, sino que se habían rejuvenecido hasta asemejarse a las de alguien de 23 años de edad.
“Recuerdo el día que recibí los resultados y no podía creer que algunas de las células fueran 30 años más jóvenes de lo que se suponía que eran. ¡Fue un día muy emocionante!”, aseguró.
La técnica no se puede trasladar inmediatamente a la clínica porque el método IPS aumenta el riesgo de cánceres.
Pero el profesor Reik confía en que ahora que se sabe que es posible rejuvenecer las células, su equipo podrá encontrar un método alternativo más seguro.
“El objetivo a largo plazo es extender el período de salud humana, en lugar de la duración de la vida, para que las personas puedan envejecer de una manera más saludable”, dijo.
Los usos
El profesor Reik dice que algunas de las primeras aplicaciones podrían ser desarrollar medicamentos para rejuvenecer la piel en personas mayores en partes del cuerpo donde se han cortado o quemado, como una forma de acelerar la curación.
Los investigadores han demostrado que esto es posible en principio al mostrar que sus células de piel rejuvenecidas se mueven más rápidamente en experimentos que simulan una herida.
El siguiente paso es ver si la tecnología funcionará en otros tejidos como los músculos, el hígado y las células sanguíneas.
La profesora Melanie Welham, presidenta ejecutiva del Consejo de Investigación de Biotecnología y Ciencias Biológicas de Reino Unido, que financió en parte la investigación que condujo a la oveja Dolly, le dijo a la BBC que los beneficios clínicos de la tecnología, estancados durante mucho tiempo, pueden no estar tan lejos.
“Si enfoques similares o nuevas terapias pudieran rejuvenecer las células inmunitarias, que sabemos que se vuelven menos sensibles a medida que envejecemos, entonces en el futuro podría ser posible aumentar la respuesta de las personas a la vacunación, así como su capacidad para combatir infecciones”.
En búsqueda de la “fuente de la juventud”

La gran pregunta es si los esfuerzos de investigación en esta área conducirán a un método de regeneración de todo el cuerpo, un elixir de la juventud o una píldora antienvejecimiento.
El profesor Reik dijo que esta idea no era del todo descabellada.
“La técnica se ha aplicado a ratones genéticamente modificados y hay algunos signos de rejuvenecimiento. Un estudio mostró signos de un páncreas rejuvenecido, lo que es interesante por su potencial para combatir la diabetes”.
Pero el profesor Robin Lovell-Badge, del Instituto Crick de Londres, cree que los obstáculos son considerables.
Tampoco cree que sea un proceso trivial trasladar el proceso de rejuvenecimiento a otros tipos de tejido o, de hecho, a una píldora antienvejecimiento.
“Si encuentras otros químicos que hagan lo mismo, eso sería bueno, pero pueden ser igual de malos. Por lo tanto, es ambicioso pensar que encontrará estos productos químicos fácilmente y que serán más seguros.
“También es muy posible que otros tipos de células requieran condiciones diferentes que pueden ser difíciles de controlar. Y si pudieras hacerlo con todo el cuerpo de manera segura, falta tanto tiempo que creo que es pura especulación”.
Otras noticias de BBC MUNDO
En Marruecos. El fastuoso palacio que Epstein intentó comprar días antes de su arresto
Red de abusos. La historia de la enigmática Ghislaine Maxwell, rica heredera y única condenada por el caso Epstein
Por qué la Argentina es un caso aparte. Cómo se compara la semana laboral de 40 horas aprobada en México con el resto de América Latina
- 1
Subasta sin compradores: el Gobierno no logró vender el terreno de la polémica en Almagro
2Comenzaron las obras: así será el nuevo espacio verde que beneficiará a 70.000 vecinos y promete transformar la zona norte de la Ciudad
- 3
Cómo impacta la genética en la longevidad y qué otros factores ayudan a lograrla
4Paro de controladores aéreos: se levantó la medida de fuerza de hoy, pero sigue activo el cese de actividades a partir del sábado








